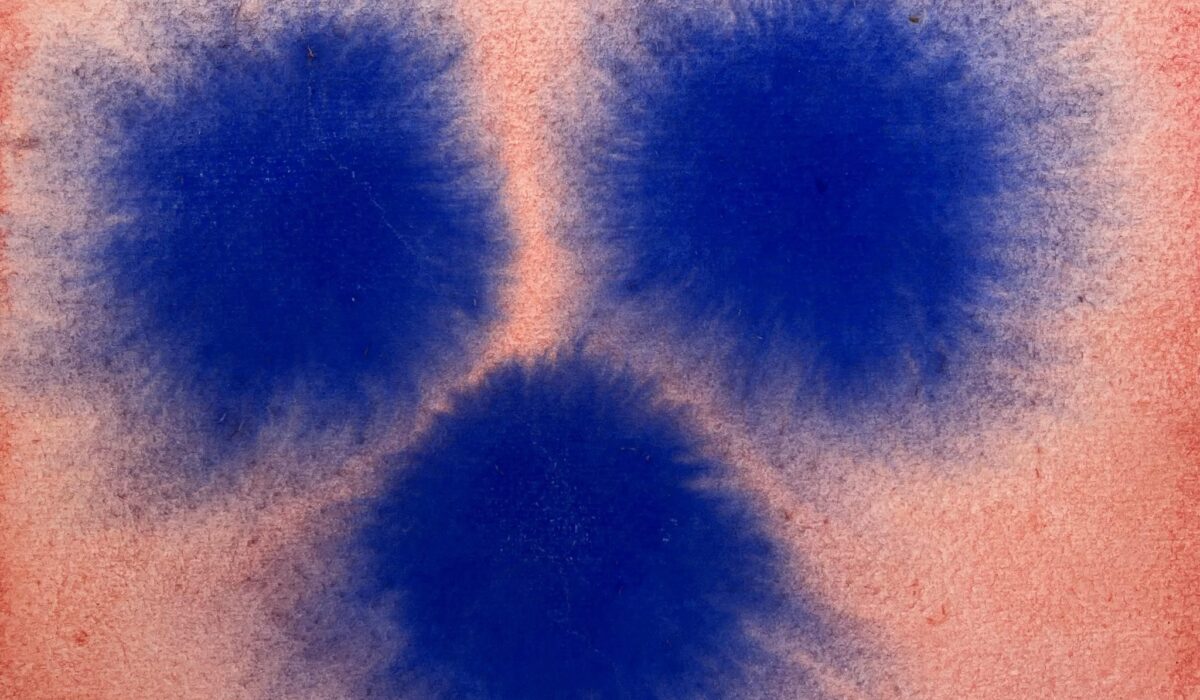
648095896 122176728524758867 928540518862836726 n

Gouda, Kunstliefhebbers opgelet! Op zaterdag 11 en zondag 12 april van 12 tot 17 uur gonst het weer in het Goudse centrum en ademt de stad weer KUNSTMOMENT! Dit jaarlijks terugkerend evenement wordt georganiseerd door kunstenaars zelf en staat garant voor een weekend vol ontmoeting, verrassing en inspiratie in de Goudse kunsten.
Maar liefst 54 kunstenaars stellen hun ateliers open op 26 locaties. Deze zijn gemakkelijk te herkennen aan de fluorroze vlag!
Iedereen kan een kijkje komen nemen in de werkruimten, kennisnemen van werk in wording, manier van werken en (nieuwste) werken en projecten. Dwalen door de stad, ateliergebouwen, achterafwerkplekken, je komt nog eens ergens. Er is veel te zien en natuurlijk zijn de kunstenaars zelf aanwezig!
Naast de individuele werkplaatsen zijn atelierverzamelgebouw De Spoel en Lethmaet open en doen zowel de Oude Begraafplaats als GOUDasfalt mee. Speciaal dit weekend vaart het pontje u het hele weekend naar de overkant aan de IJssel (en weer terug). Natuurlijk is ook De Firma | Kunstcentrum Gouda open voor publiek.
Deelnemende kunstenaars en plattegrond
Een overzicht van de deelnemende kunstenaars vindt u op Instagram en Facebook.
Hier vindt u het PLATTEGROND met ateliers.
Wilt u vooraf vast een plattegrond ophalen? Dat kan bij De Firma, Achter de Kerk 13, open donderdag tot en met zondag van 12 tot 17 uur.
We sluiten feestelijk af!
Na een inspirerend weekend vol kunst sluiten we op zondag 12 april af met een gezellige borrel bij de Firma, vanaf 17:15 uur. Alle kunstenaars en bezoekers zijn van harte welkom om samen te toasten op een geslaagd evenement!
Bewonder en beleef kunst in Gouda tijdens KUNSTMOMENTgouda!
- “Laten we allemaal even een moment voor de kunst nemen, oké… we nemen een weekend!”
- Volg ons op op Instagram, Facebook en artgouda.com/kunstmomentgouda/
- Voor meer informatie: arjenne.vossepoel@gmail.com